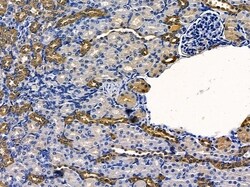
Invitrogen OR10G2 Polyclonal Antibody 100 &mu;L; Unconjugated:Antibodies,

missing translation for 'onlineSavingsMsg'
Learn More
Learn More
Invitrogen™ OR10G2 Polyclonal Antibody


Rabbit Polyclonal Antibody
Brand: Invitrogen™ PA5102115
This item is not returnable.
View return policy
Description
Antibody detects endogenous levels of total OR10G2.
Olfactory receptors interact with odorant molecules in the nose, to initiate a neuronal response that triggers the perception of a smell. The olfactory receptor proteins are members of a large family of G-protein-coupled receptors (GPCR) arising from single coding-exon genes. Olfactory receptors share a 7-transmembrane domain structure with many neurotransmitter and hormone receptors and are responsible for the recognition and G protein-mediated transduction of odorant signals. The olfactory receptor gene family is the largest in the genome. The nomenclature assigned to the olfactory receptor genes and proteins for this organism is independent of other organisms.
Specifications
| OR10G2 | |
| Polyclonal | |
| Unconjugated | |
| OR10G2 | |
| olfactory receptor 10G2; olfactory receptor family 10 subfamily G member 2; olfactory receptor OR14-41 pseudogene; olfactory receptor, family 10, subfamily G, member 2; OR10G2; OR14-41 | |
| Rabbit | |
| Affinity chromatography | |
| RUO | |
| 26534 | |
| -20°C | |
| Liquid |
| Immunohistochemistry (Paraffin), Western Blot, Immunocytochemistry | |
| 1 mg/mL | |
| PBS with 50% glycerol and 0.02% sodium azide; pH 7.4 | |
| Q8NGC3 | |
| OR10G2 | |
| A synthesized peptide derived from human OR10G2(Accession Q8NGC3), corresponding to amino acid residues S244-T294. | |
| 100 μL | |
| Primary | |
| Human, Mouse, Rat | |
| Antibody | |
| IgG |
Product Content Correction
Your input is important to us. Please complete this form to provide feedback related to the content on this product.
Product Title
Spot an opportunity for improvement?Share a Content Correction